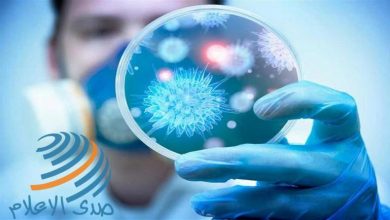

الصحة العالمية: نستعد لجولة اخرى من فايروس “كورونا”

في تحذير جديد صادم وبعد رفع العديد من الدول الأوروبية القيود وتخفيف اجراءات الحظر التي فرضت سابقا من أجل مواجهة الفيروس المستجد، قالت منظمة الصحة العالمية، إنه يجب على الدول الأوروبية أن تستعد لموجة ثانية قاتلة من الإصابات بفيروس كورونا، لأن الوباء لم ينته بعد.
ووجه المدير الإقليمي للمنظمة في أوروبا هانز كلوغ، تحذيرا صارخا إلى البلدان التي بدأت في تخفيف قيود الإغلاق، قائلا إن الوقت الآن هو “وقت التحضير، وليس الاحتفال”، وفق قناة (العربية).
وحذر من أن بؤرة التفشي الأوروبي تقع الآن في الشرق، مع ارتفاع عدد الحالات في روسيا وأوكرانيا وبيلاروسيا وكازاخستان.
وشدد على ضرورة أن تبدأ الدول في تعزيز أنظمة الصحة العامة وكذلك بناء القدرات في المستشفيات والرعاية الأولية ووحدات العناية المركزة.
وأضاف أن “دولا مثل سنغافورة واليابان فهمت في وقت مبكر أن هذا ليس وقتا للاحتفال، إنه وقت التحضير، وهذا ما تفعله الدول الاسكندنافية”.
كما حذر من أن الموجة الثانية قد تكون مزدوجة ويمكن أن تتزامن مع تفشي أمراض معدية أخرى، كالإنفلونزا الموسمية أو الحصبة.